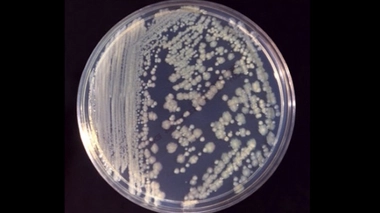
En cause : des bactéries Enterobacter cloacae dans les poches de nutrition

5% des patients hospitalisés touchés par une infection nosocomiale
Depuis cinq ans, le nombre d'infections nosocomiales reste relativement stable en France, selon une étude de Santé publique France.
Par La rédaction d'Allo Docteurs
Mis à jour le
Un patient hospitalisé sur 20 serait porteur d’au moins une infection nosocomiale (voir encadré), selon les conclusions de la 6e enquête nationale sur ce type d’infection, présentée ce 4 juin par Santé publique France. La prévalence de ces infections est stable depuis cinq ans. Les trois quarts d'entre elles surviennent sur le site où l’infection est identifiée, le dernier quart étant "importé d’un autre établissement".
Les risques de contracter une infection nosocomiale varie fortement en fonction des services hospitaliers. Ainsi, les services de réanimation qui reçoivent des patients plus vulnérables et exposés à de multiples dispositifs invasifs sont particulièrement à risque. "Dans ces services, près d’un patient sur quatre est porteur d’au moins une infection nosocomiale", selon l'enquête de Santé Publique France, réalisée entre mai et juin 2017 auprès de 403 établissements de santé et 80.988 patients.
La chirugie orthopédique à risque
À l’échelle des établissements, plus d’une infection sur quatre serait urinaire. Les infections pulmonaires et celles survenant après chirurgie, au niveau de la zone opérée, sont ensuite les plus fréquentes. Toutefois, "toutes n’ont pas le même degré de gravité", précise l’agence. "Les infections urinaires très fréquentes sont le plus souvent anodines malgré la gêne occasionnée. À l’inverse, des infections survenant par exemple lors de chirurgie orthopédique sont plus graves." C'est le cas des poses de prothèse de genou ainsi que la chirurgie des varices des membres inférieurs.
"Les patients avec un dispositif invasif (cathéter, sonde urinaire, assistance respiratoire) ont un risque d’être infectés 4,6 fois supérieur à celui des patients sans dispositif invasif", poursuivent les auteurs du rapport. "Trois bactéries sont le plus fréquemment responsables d’une infection nosocomiale : Escherichia coli (près de 25% des infections), staphylocoque doré (13%), Enterococcus faecalis (6,5%)." Selon les données collectées, les patients âgés de 65 à 84 ans auraient 2,5 fois plus de risque d’être infectés que les autres.
Comparée aux données de la précédente enquête, réalisée en 2012, la prévalence globale des patients infectés est demeurée stable. Ce chiffre masque toutefois une diminution en soins longue durée (-25%) ainsi qu’en soins de suite et réadaptation (-19%), tandis qu’une augmentation est notée en court séjour (+12%) et en chirurgie (+35%).
Selon des travaux de 2004, les infections nosocomiales seraient chaque année la cause directe d’environ 4.000 décès en France.
la rédaction d'Allodocteurs.fr
Une infection nosocomiale est une infection contractée au cours d’un séjour dans un établissement de santé (hôpital, clinique...), qui survient au cours d’une prise en charge (diagnostique, thérapeutique, palliative, préventive...).